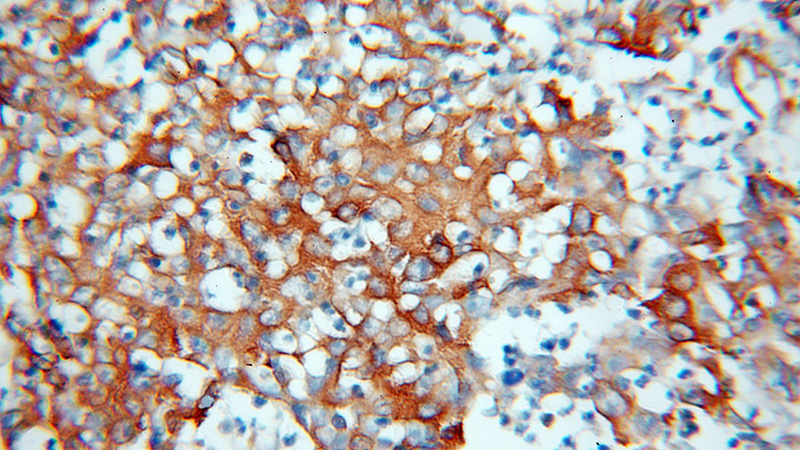
Immunohistochemical of paraffin-embedded human colon cancer using Catalog No:114905(RPLP0 antibody) at dilution of 1:100 (under 10x lens)

-
Product Name
RPLP0 antibody
- Documents
-
Description
RPLP0 Rabbit Polyclonal antibody. Positive IHC detected in human colon cancer tissue. Positive WB detected in HeLa cells, rat liver tissue. Positive IP detected in HeLa cells. Observed molecular weight by Western-blot: 34 kDa
-
Tested applications
ELISA, WB, IHC, IP
-
Species reactivity
Human,Mouse,Rat; other species not tested.
-
Alternative names
60S ribosomal protein L10E antibody; L10E antibody; PRLP0 antibody; ribosomal protein antibody; large antibody; RPLP0 antibody; RPP0 antibody
-
Isotype
Rabbit IgG
-
Preparation
This antibody was obtained by immunization of RPLP0 recombinant protein (Accession Number: NM_053275). Purification method: Antigen affinity purified.
-
Clonality
Polyclonal
-
Formulation
PBS with 0.1% sodium azide and 50% glycerol pH 7.3.
-
Storage instructions
Store at -20℃. DO NOT ALIQUOT
-
Applications
Recommended Dilution:
WB: 1:1000-1:10000
IP: 1:200-1:2000
IHC: 1:20-1:200
-
Validations

HeLa cells were subjected to SDS PAGE followed by western blot with Catalog No:114905(RPLP0 antibody) at dilution of 1:300
Immunohistochemical of paraffin-embedded human colon cancer using Catalog No:114905(RPLP0 antibody) at dilution of 1:100 (under 10x lens)

IP Result of anti-RPLP0 (IP:Catalog No:114905, 4ug; Detection:Catalog No:114905 1:500) with HeLa cells lysate 4000ug.
-
Background
RPLP0 is first identified as a cytosolic protein which takes a part in the ribosomal stalk and interacts with RPLP1 and RPLP2. It also has potential roles in molecular transport from outside into the cells. It generally presents in multiple copies on the ribosome and have isoelectric points in the range of pH 3 to 5, in contrast to most ribosomal proteins, which are single copy and basic
-
References
- Yun C, Wang Y, Mukhopadhyay D. Nucleolar protein B23/nucleophosmin regulates the vertebrate SUMO pathway through SENP3 and SENP5 proteases. The Journal of cell biology. 183(4):589-95. 2008.
- Dufour CR, Levasseur MP, Pham NH. Genomic convergence among ERRα, PROX1, and BMAL1 in the control of metabolic clock outputs. PLoS genetics. 7(6):e1002143. 2011.
- Charest-Marcotte A, Dufour CR, Wilson BJ. The homeobox protein Prox1 is a negative modulator of ERR{alpha}/PGC-1{alpha} bioenergetic functions. Genes & development. 24(6):537-42. 2010.
- Nguyen VA, Le T, Tong M, Silbermann E, Gundogan F, de la Monte SM. Impaired insulin/IGF signaling in experimental alcohol-related myopathy. Nutrients. 4(8):1058-75. 2012.
- Tong M, Longato L, Ramirez T, Zabala V, Wands JR, de la Monte SM. Therapeutic reversal of chronic alcohol-related steatohepatitis with the ceramide inhibitor myriocin. International journal of experimental pathology. 95(1):49-63. 2014.
- Tan GS, Lim KH, Tan HT. Novel proteomic biomarker panel for prediction of aggressive metastatic hepatocellular carcinoma relapse in surgically resectable patients. Journal of proteome research. 13(11):4833-46. 2014.
- Perry MC, Dufour CR, Eichner LJ. ERBB2 deficiency alters an E2F-1-dependent adaptive stress response and leads to cardiac dysfunction. Molecular and cellular biology. 34(23):4232-43. 2014.
- Eichner LJ, Perry MC, Dufour CR. miR-378(∗) mediates metabolic shift in breast cancer cells via the PGC-1β/ERRγ transcriptional pathway. Cell metabolism. 12(4):352-61. 2010.
Related Products / Services
Please note: All products are "FOR RESEARCH USE ONLY AND ARE NOT INTENDED FOR DIAGNOSTIC OR THERAPEUTIC USE"
